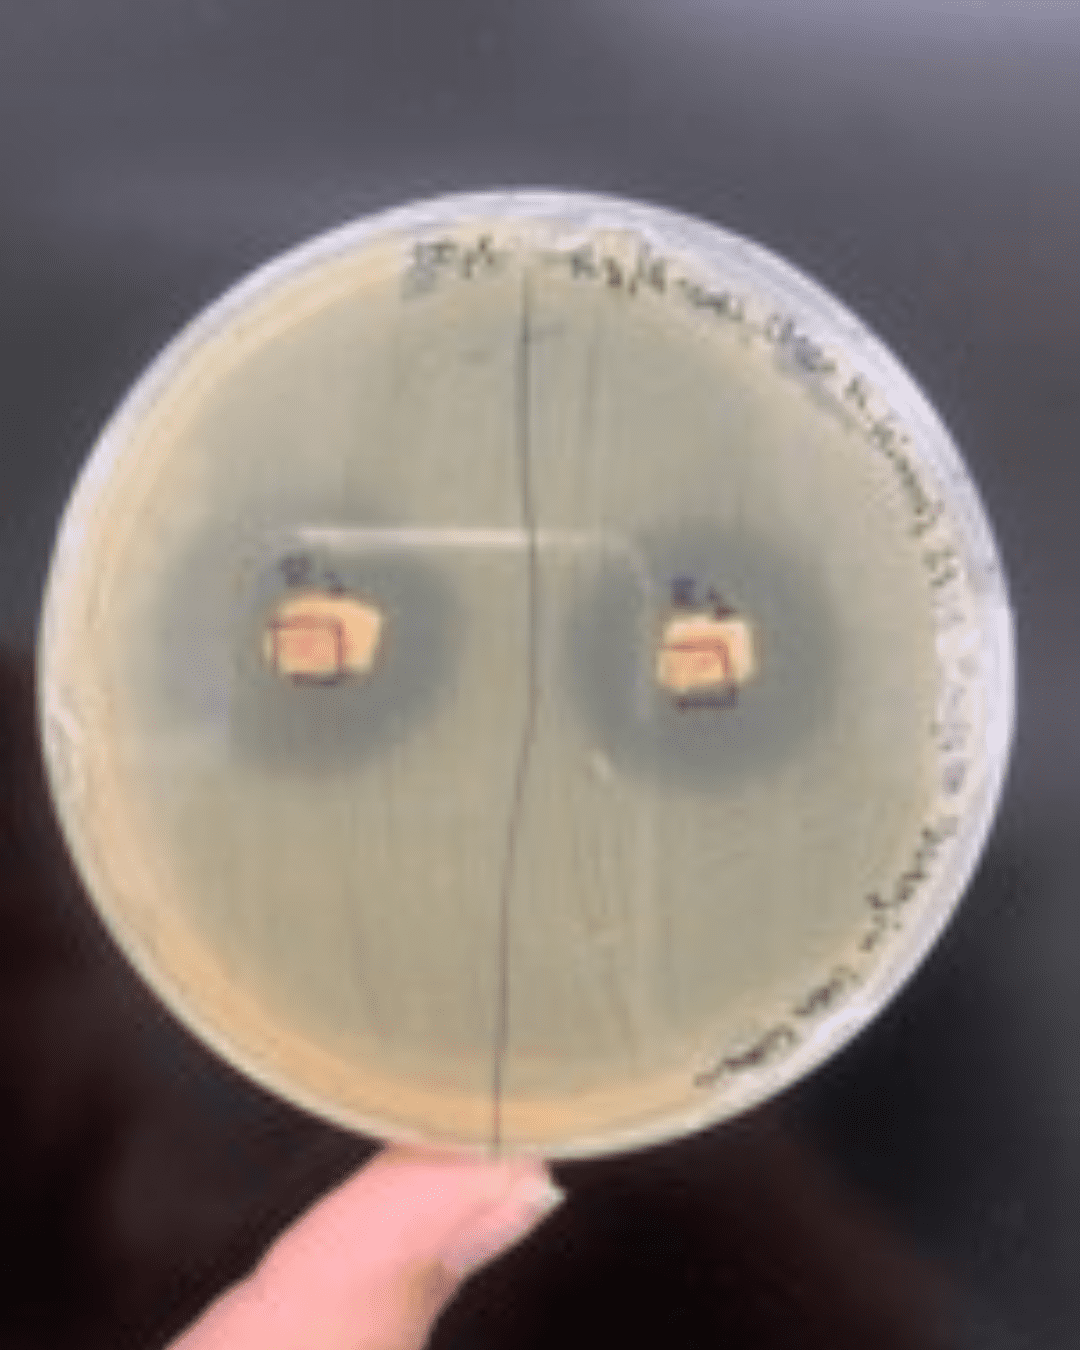

Research project at the Lusófona University Organic Garden
Students and professors analyse isolation of soil Microorganisms with Antimicrobial Activity
10.07.24 - 14h08

Between March and June, Universidade Lusófona launched a new research project at its Organic Garden, aiming to explore soil properties and the microbial communities present. Coordinated by Professors Elisabete Maurício and Patrícia Branco, the project involves the participation of several students from the Eco-Schools programme.
The research will focus on isolating soil microorganisms with antimicrobial activity with the aim of identifying microorganisms that may have the potential to combat pathogens, contributing to advances in the field of biological and pharmaceutical sciences. The data obtained will be used for publication in international journals with scientific arbitration, underlining the relevance and quality of the work carried out.
The organic garden, already recognised for its educational and sustainable role, serves as an ideal environment for this type of research. The students involved are learning about the bioactive properties of plant extracts and contributing to the development of new solutions in biotechnology.
This project offers a valuable opportunity for the academic and scientific training of our students, contributing to their academic and professional future.











